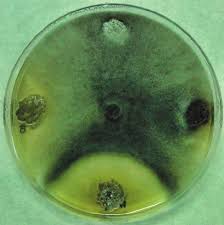

Universidad de León
Instituto de Investigación
de la viña y el vino
El grupo de trabajo está formado por personal investigador de la propia Universidad de León.
PUBLICACIONES
2017

Use of endophytic and rhizosphere actinobacteria from grapevine plants to reduce nursery fungal graft infections that lead to young grapevine decline.
José Manuel Álvarez-péres, Sandra González-García, Rebeca Cobos, Miguel Ángel Olego, Ana Ibañez, Alba Díez-Galán, Enrique Garzón-Jimeno, Juan José R. Coque.
Applied and Environmental Microbiology. 2017, Volume 83 Issue 24.

The addittion of leonardites, an alternative organic amendment to manures, increases soil available phosphorus levels in vineyard calcareous soils.
M.A. Olego, M.J. Quiroga, M. Sánchez-García, J.E. Medina, J.E. Garzón Jimeno.
Agricultural Research Updates. 2017, Volume 15.

Effects of liming on soil properties, leaf tissue cation composition and grape yield in a moderately acid vineyard soil. Influence on must and wine quality.
Miguel Javier Quiroga, Miguel Ángel Olego, Mario Sánchez-García, Jesús Esteban Medina, Fernando Visconti, Juan José Rubio Coque and José Enrique Garzón Jimeno.
OENO ONE. Vine and Wine open access journal. 2017. Volume 51, Nº 3.

¿Qué es la viticultura 4.0?
M. Sánchez-García, Jesús E. Medina, Miguel Ángel Olego Morán, Miguel Javier Quiroga Martínez, Rebeca Cobos Morán, José Manuel Álvarez-Pérez, J.J.R. Coque, José Enrique Garzón Jimeno.
Tierras de Castilla y León: Agricultura. 2017. Nº 253. págs. 84-85.
2016

Use of endophytic and rhizosphere actinobacteria from grapevine plants to reduce nursery fungal graft infections that lead to young grapevine decline.
José Manuel Álvarez-péres, Sandra González-García, Rebeca Cobos, Miguel Ángel Olego, Ana Ibañez, Alba Díez-Galán, Enrique Garzón-Jimeno, Juan José R. Coque.
Applied and Environmental Microbiology. 2017, Volume 83 Issue 24.

The addittion of leonardites, an alternative organic amendment to manures, increases soil available phosphorus levels in vineyard calcareous soils.
M.A. Olego, M.J. Quiroga, M. Sánchez-García, J.E. Medina, J.E. Garzón Jimeno.
Agricultural Research Updates. 2017, Volume 15.

Effects of liming on soil properties, leaf tissue cation composition and grape yield in a moderately acid vineyard soil. Influence on must and wine quality.
Miguel Javier Quiroga, Miguel Ángel Olego, Mario Sánchez-García, Jesús Esteban Medina, Fernando Visconti, Juan José Rubio Coque and José Enrique Garzón Jimeno.
OENO ONE. Vine and Wine open access journal. 2017. Volume 51, Nº 3.

¿Qué es la viticultura 4.0?
M. Sánchez-García, Jesús E. Medina, Miguel Ángel Olego Morán, Miguel Javier Quiroga Martínez, Rebeca Cobos Morán, José Manuel Álvarez-Pérez, J.J.R. Coque, José Enrique Garzón Jimeno.
Tierras de Castilla y León: Agricultura. 2017. Nº 253. págs. 84-85.
2015
Use of endophytic and rhizosphere actinobacteria from grapevine plants to reduce nursery fungal graft infections that lead to young grapevine decline.
José Manuel Álvarez-péres, Sandra González-García, Rebeca Cobos, Miguel Ángel Olego, Ana Ibañez, Alba Díez-Galán, Enrique Garzón-Jimeno, Juan José R. Coque.
Applied and Environmental Microbiology. 2017, Volume 83 Issue 24.

The addittion of leonardites, an alternative organic amendment to manures, increases soil available phosphorus levels in vineyard calcareous soils.
M.A. Olego, M.J. Quiroga, M. Sánchez-García, J.E. Medina, J.E. Garzón Jimeno.
Agricultural Research Updates. 2017, Volume 15.

Effects of liming on soil properties, leaf tissue cation composition and grape yield in a moderately acid vineyard soil. Influence on must and wine quality.
Miguel Javier Quiroga, Miguel Ángel Olego, Mario Sánchez-García, Jesús Esteban Medina, Fernando Visconti, Juan José Rubio Coque and José Enrique Garzón Jimeno.
OENO ONE. Vine and Wine open access journal. 2017. Volume 51, Nº 3.

¿Qué es la viticultura 4.0?
M. Sánchez-García, Jesús E. Medina, Miguel Ángel Olego Morán, Miguel Javier Quiroga Martínez, Rebeca Cobos Morán, José Manuel Álvarez-Pérez, J.J.R. Coque, José Enrique Garzón Jimeno.
Tierras de Castilla y León: Agricultura. 2017. Nº 253. págs. 84-85.